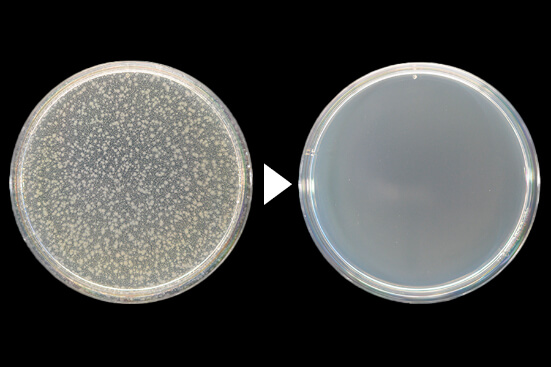
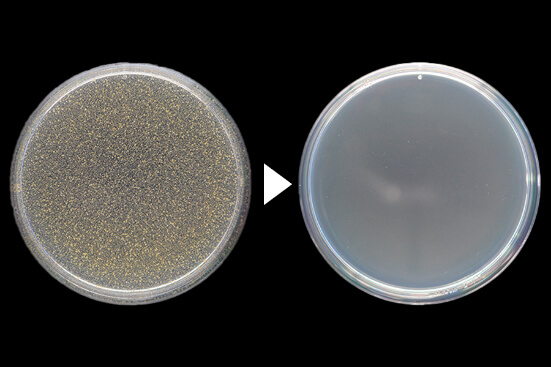

5分でこの違い!驚きの殺菌効果!
十美LAB ハンドクリア 除菌効果試験データ

左:実験開始前 右:実験 5分後

左:実験開始前 右:実験 5分後
※潤ってキメの整った手の状態



















【全成分】
エタノール、水、グリセリン、(アクリロイルジメチルタウリン
アンモニウムV/P)コポリマー、サクシノイルアテロコラーゲン
70~80%濃度エタノールは、他の濃度に比べ 内部への浸透性が強く、最も強い殺菌性があ ると確かめられています。また、液体よりも アルコールが蒸発しにくいジェルタイプのた め、効果の持続も期待できます。
十美LAB ハンドクリア 除菌効果試験データ

アルコールジェルなのにしっとりしているのは、保湿成分のサクシノイルアテロコラーゲン配合だから。通常のコラーゲンは3重線の構造ですが、アテロコラーゲンは3重の線がらせん状の構造のため、密度がしっかり。
清潔感のある、うるおいのある手指へ。

十美LABハンドクリアの全シリーズ、全て千葉県松戸市の工場で製造されています。徹底した品質管理のもと、お客様へお届け致します。
注射の際に塗布されるアルコールと原料は同じなのでご使用に問題はありませんが、赤みが出ることがございます。使いはじめは少量にするなど、様子をみながら使用されることをお勧めします。
また、ハンドクリアを塗布した後、清潔なタオルやハンカチで拭くと、雑菌がより落ちることがわかっています。

